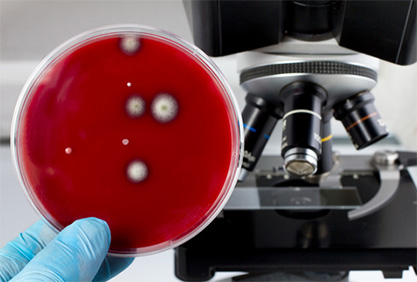

natürliche Schimmelbeseitigung
Schimmelbeseitigung ohne Gifte
Schimmelpilze in Innenräumen stellen nicht nur ein optisches Problem dar. Sie können auch die Gesundheit der Bewohner gefährden. Schimmelpilze und deren Stoffwechselprodukte können beim Menschen zu Atemwegserkrankungen oder Allergien führen. Risikogruppen können kleine Kinder, ältere Menschen oder Personen mit geschwächtem Immunsystem sein. Hausstaubmilben und Schimmelpilzsporen stellen die wichtigsten Allergene der Innenraumluft dar. Daher gilt: Liegt ein Schimmelbefall vor, sollten sofort Maßnahmen zur Beseitigung des Befalls sowie der Ursachen für das Schimmelpilzwachstum ergriffen werden. Ein Schimmelpilzbefall sollte immer kurzfristig und zeitnah beseitigt werden, um ein starkes Aussporen nach der Reife des Fruchtkörpers zu verhindern. Wichtig dabei ist auf chemische Produkte, die Fungi- und Bakterizide oder gar Chlor enthalten, zu verzichten, da diese desinfizierenden Stoffe mitunter schädlicher sind als der Befall selbst, denn Chlor ist ein Nervengift und Fungizide können ausgasen. Da bei einem Befall immer mehrere Parameter eine Rolle spielen, können keine pauschalen Ursachenklärungen getroffen werden. Wir bieten eine umfassende messtechnische Analytik und führen darauf basierend geeignete Instandsetzungsmaßnahmen durch. Leistungsspektrum:
- Sachkundenachweis für Schimmelpilzbeseitigung
- Bauchemische und labortechnische Kennwerte
- Bestimmung der Art des organischen Befalls: Schimmelpilze, Pilze; Hefe, Algen
- Mikroskopische Identifizierung von Schimmelpilzen und Einschätzung des Gefährdungspotentials
- Bauphysikalische Kennwerte durch Messungen vor Ort
- Temperatur- und Feuchtetechnische einmal Messungen mit Bestimmung des Taupunktes
- Klimadatenlangzeiterfassung und Auswertung Erstellen und Ausführen des Instandsetzungsvorschlages
Info zu unserem Kalk-Schimmelsaniermörtel